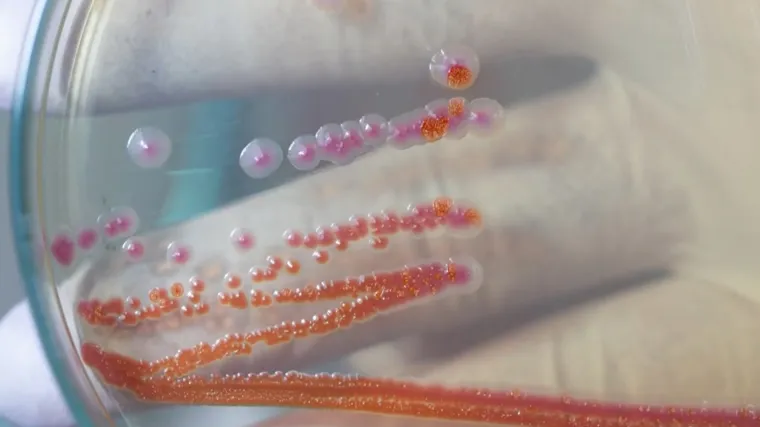
Strani radnik u Splitu zaražen gubom. 'Građani su imali pravo biti pravodobno informirani'

BUDITE OPREZNI /
Vatrogasci savjetovali kako smanjiti rizik od požara: 'Nema potrebe da svijetle sami za sebe'
Teroristički napad u Australiji usred bijela dana. Na plaži u Sydneyu za vrijeme proslave prvog dana židovskog blagdana Hanuke ubijeno je najmanje 12 osoba.
Deseci su ranjeni, jedan je napadač Uhićen, a drugi ubijen. Ovo je jedan u nizu napada na Židove u toj zemlji zbog čega je reagirala izraelska vlada.
"Nažalost, ovaj ubojiti napad u Sydneyju bio je predvidiv. Dvije godine na ulicama Australije, posebno u Sydneyju, održavani su antisemitski prosvjedi", rekao je Gideon Saar, izraelski ministar vanjskih poslova.
Neke od snimaka bi vas mogle uznemiriti. Više saznajte u prilogu Laure Damnjanović Šalamon.